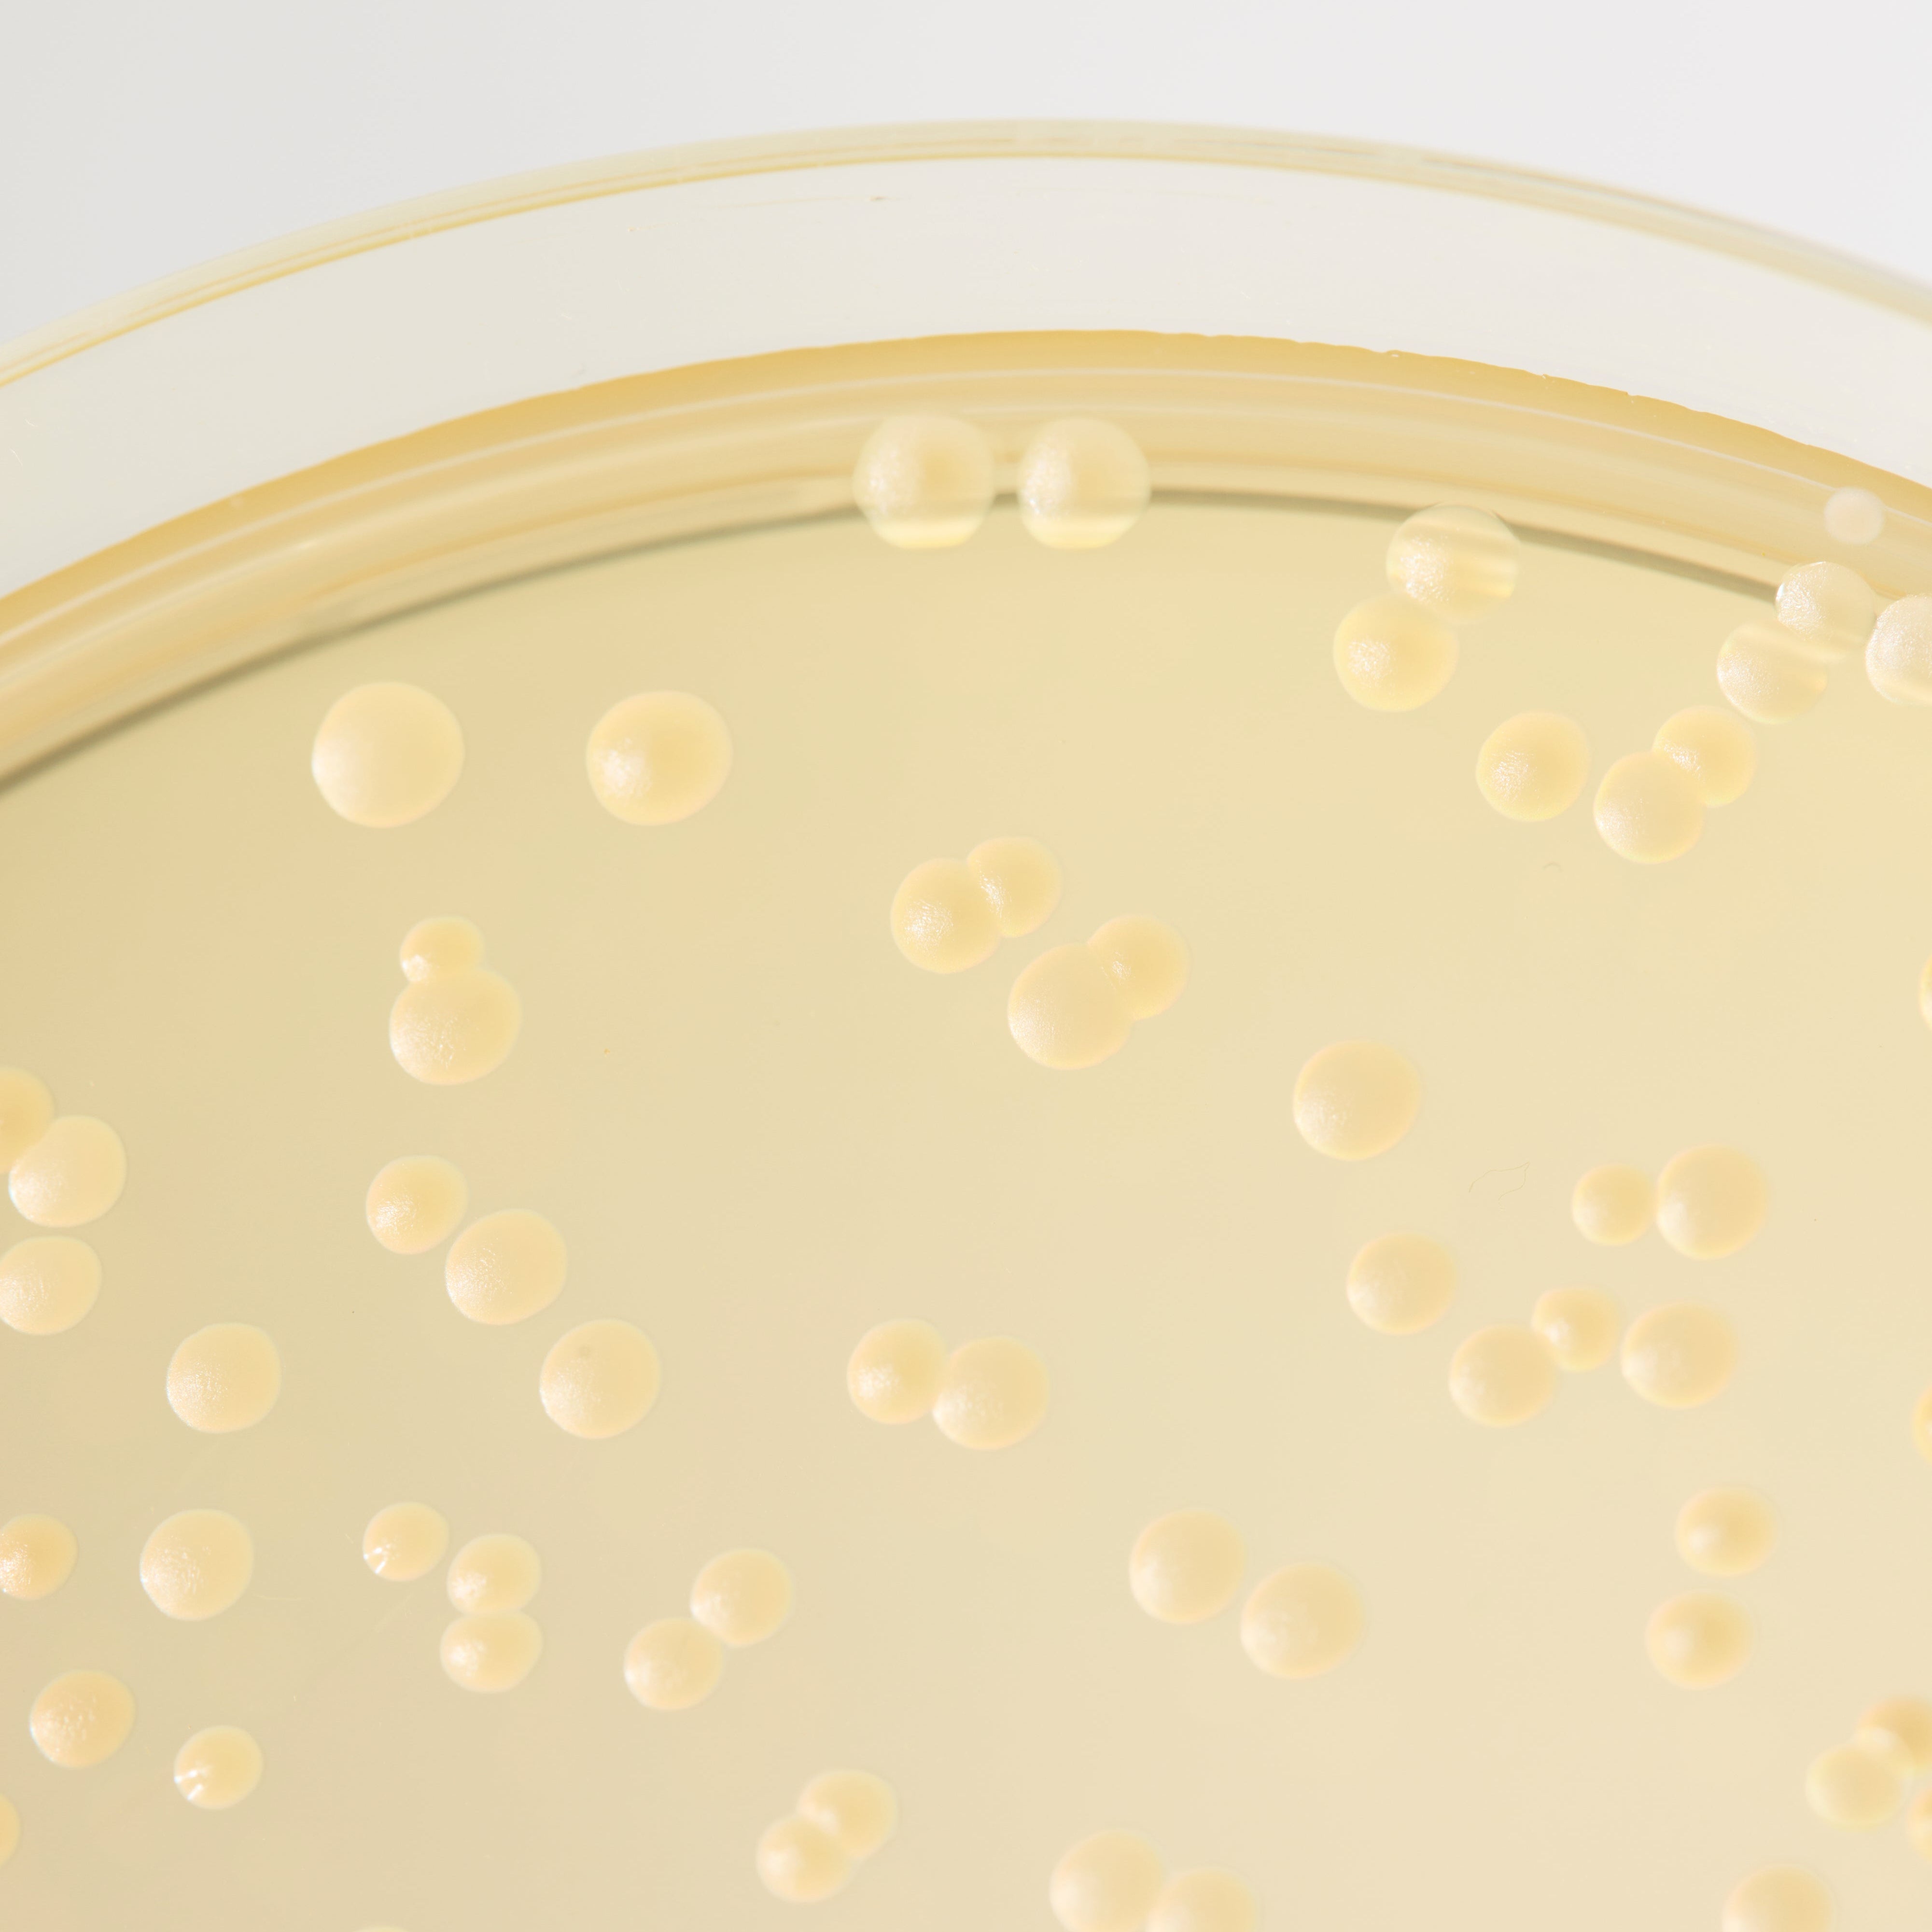

New! BioGaia® Prodentis® KIDS
Apple-flavoured probiotic lozenges to support healthy teeth and gums.


Probiotic supplements supported by science
Our range of probiotic supplements have been developed by our expert team of doctors, immunologists and microbiologists. Behind each of our products you will find more than 200,000 hours of world-leading probiotic and gut microbiome research.
Wellness for the whole family!



Reviews
Explore our latest reads
Postpartum poop – everything you need to know
Let’s talk about something many new mums think about but rarely discuss openly: pooping after birth. It may not be glamorous, but your bowel habits are...
Benefits of kissing – How your love life affects your body and mind
While the magic of kissing needs no introduction, research now suggests that kissing is more than just a sign of affection—it can be potentially beneficial...
What are baby sleep routines and how do they work?
Sleep, and the lack of it, is a constant topic among parents. The questions are many when it comes to implementing a sleep routine for your baby, and the amount of contradictory...
A guide to balancing and supporting the skin microbiome
Our skin is home to billions of tiny organisms – bacteria, fungi, and even viruses – collectively known as the skin microbiome. Far from being...
How to help a teething baby: tips for sleep and soothing pain
When your baby begins the slow process of getting their first teeth, it may result in a loss of appetite, crying and clinginess – and...
Understanding baby cries: what is your baby trying to say?
Heidi Skudder is one of the UK’s leading early years parent coaches. In this article, we asked her to go through the most common reasons for...



































































































